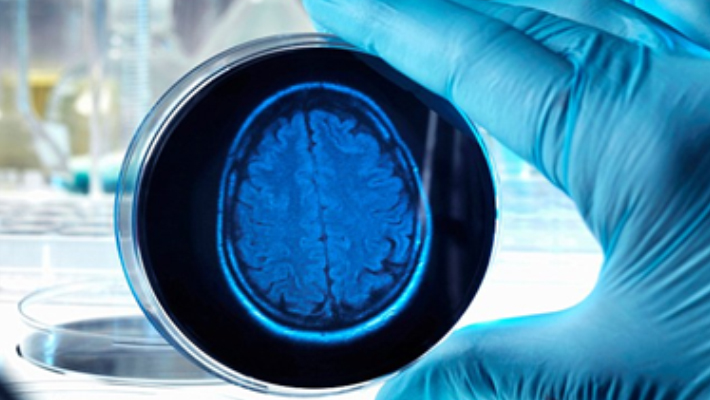

Omiljeni napitak širom sveta, kafa je hvaljena, opevana čak i upesmama i neizostavni je deo ritual razbuđivanja ljudi. Iako kafa sadrži antioksidanse, njene zdravstvene koristi se ...

Izgleda da ni korišćenje lakova za nokte više nije bezopasan način ulepšavanja. Način proizvodnje lakova za nokte se od njihovog pronalaska značajno promenio i oni danas sadrže različite hemikalije ...

Poznato je da antibiotike ne treba uzimati na svoju ruku, već samo prema strogim indikacijama, na preporuku lekara koji bi, osim u životno kritičnim situacijama, trebalo da ih prepiše ...
Svaka osoba reaguje ii ma drugačije navike kada je probava u pitanju, i svima je jasno da postoje mnogobrojni i najraznovrsniji činioci koji podstiču ubrzanje rada creva. Čuvena i svetski ...

Budući da ne mogu da žvaću, muve traže (i pronalaze) onu hranu koju mogu da rastapaju enzimima, ispljunu i zatim usisaju. A pretpostavljamo da svi znate šta je muvama omiljena ...

Moždani udar je jedan od najznačajnijih uzroka smrtnosti i invalidnosti u našoj i u zemljama regiona. Svake dve sekunde neko u svetu doživi moždani udar, a svakih šest ...

Naučnici su nedavno u zaštitnoj sluzi jedne vrste indijske žabe otkrili supstancu koja efikasno uništava virus gripa, i koja bi uskoro mogla biti pretvorena u moćan lek protiv ove infektivne ...

Buđ ili plesan je u većini slučajeva pouzdan pokazatelj da se hrana pokvarila id a nije za upotrebu, a većina osoba će odlučiti da baci hranu koja je pobuđala, što je u većini slučajeva ispravna ...

Iz dana u dan ste iznenađeni kako brzo dođe vreme za spavanje, a da mi nismo stigli da učinimo ni polovinu od onog što smo zacrtali i želeli tog dana. Ali pre nego što se počnete da se osećate ...

Narod Tsimané koji živi u šumama Bolivije najređe boluje od kardiovaskularnih oboljenja na svetu, tvrde naučnici u istraživanju koje je nedavno objavljeno u britanskom medicinskom ...

Naučnici su otkrili način kako da od lista spanaća bioinženjerskom metodom stvore funkcionalno tkivo ljudskog srčanog mišića, što bi u budućnosti moglo značajno doprineti rešavanju ...

Sudeći prema rezultatima nedavno objavljene studije, naučnici su napravili veliki korak u borbi protiv AIDS – a. Iako je istraživanje još na samom početku, a dobijeni rezultati mogu ...

Osobe koje izbegavaju ishranu namirnica bogatih glutenom su izložene značajno većem riziku oboljevanja od dijabetesa tipa 2, rezultat je nedavno sprovedenog istraživanja koje su objavili ...

Devet žena iz SAD je umrlo od retkog oblika karcinoma čiji je nastanak doveden u vezu sa silikonskim implantatima u njihovim grudima, nedavno su u svom izveštaju objavili službenici ...

Novo istraživanje je pokazalo da postoji manja verovatnoća da će osobe koje umereno konzumiraju pivo oboleti od koronarne bolesti, u odnosu na one koji uopšte ne konzumiraju ovo ...

Takozvano „lomljenje prstiju“ nije retka pojava. Obično je znak nervoze, a do sada su verovatno svi već odavno čuli da ova navika nije dobra za zdravlje zglobova.

Naučnici tvrde da bi zubi uskoro mogli sami sebe da „popravljaju“ uz pomoć preparata Tideglusib, čime bi se eliminisala potreba za stavljanjem plombi, navodi se u nedavno objavljenoj studiji.

Naučnici su došli do otkrića da konzumacija alkohola pokreće u mozgu promene koje potenciraju osećaj gladi, zbog čega šalje telu signale da jede više hrane ...

Uprkos brojnim istraživanjima i novčanim ulaganjima u brojna istraživanja, karcinom je, nažalost, još uvek smrtonosna i neizlečiva bolest ...

Naučnici sa Univerziteta Kalifornija u San Dijegu su nedavno saopštili da su uspeli da otkriju molekularni mehanizam na koji metformin, stari lek za tretman dijabetesa tipa 2 deluje ...

Kapsule napunjene ćelijama koje su modifikovane metodom genetskog inženjeringa mogle bi u potpunosti izbaciti iz upotrebe injekcije insulina u tretmanu dijabetesa, pokazala je nedavno ...

Donedavno se smatralo da testosteron predstavlja svojevrsno “gorivo” za rast i napredovanje karcinoma prostate, zbog čega je cilj primene gotovo svih terapijskih protokola za lečenje ...

Osobe ženskog pola koje najmanje dva puta nedeljno uzimaju paracetamol i ibuprofen dovode sebe u objektivan rizik za nastanak ozbiljnog oštećenja sluha, zaključak je nedavno objavljene ...

Muškarca koji je decenijama smatran tzv. “nultim pacijentom” koji je virus HIV-a doneo u SAD, novo istraživanje je “oslobodilo krivice”, jer je dokazano da okrugli znak u njegovom zdravstvenom dosijeu nije označavao broj nula, nego slovo “O”.

Diacetil, hemijska supstanca koja se najčešće može naći u posebnim aromama poput karamele i butterscotcha za elektronske cigarete, smatra se odgovornom za povećan rizik oboljevanja od hroničnog bronhitisa, a stručnjaci navode da e-cigarete mogu prouzrokovati i trajno ...

Verovatno ste primetili da uvek kada pokušamo da se setimo nekog događaja iz najranijeg detinjstva, najčešće nam bude nejasno da li se mi toga zaista sećamo ili smo naknadno stvorili te slike u ...

Ravan stomak je želja mnogih osoba, i muškaraca i žena, a stručnjaci ističu da toliko željeni ravan stomak nikada nećete moći da imate ukoliko jedete pogrešnu hranu, bez obzira na redovnu fizičku ...

Nagli prestanak konzumacije šećera kod osoba koje svakodnevno uživaju u slatkišima može da izazove krizu nalik onoj koju osećaju osobe koje zloupotrebljavaju psihoaktivne supstance, tvrde australijski ...

Superbakterije će usmrtiti po jednu osobu na svake tri sekunde do 2050. godine, ukoliko ne budemo odmah reagovali, piše u izveštaju Džima O’Nila, ekonomskog savetnika premijera Velike Britanije ..

Lekari već dugo imaju nedoumice u vezi sa uzrokom nastanka sindroma hroničnog umora, patološkog stanja u kojem i sasvim uobičajene svakodnevne životne aktivnosti dovode do pojave enormnog ...

Novi projekat stručnog tima sa svetski poznatog Univerziteta Harvard i uglednog Univerziteta u Notingemu mogao bi trajno promeniti način lečenja i popravke zuba, navodi se u studiji koju je preneo ...

Ovo su neki od čuvenih mitova o hrani za koje još uvek mnogi veruju da su istiniti. Jesu li jaja zaista loša, koliko dnevno treba piti vode i je li zdravo jesti odmrznutu hranu? Nutricionistica Džulijet Kelou je...

Posle brojnih negativnih komentara i analiza stručnjaka u vezi sa novom planetarnom opsesijom, stižu i povoljne vesti: naučnici su tri meseca pratili aktivnost skoro 32.000 igrača “Pokemon Go” igrice i otkrili ...

Sve što proživljavamo na psihološkom planu, mora se neizostavno odraziti i na našem telu, zaključak je istraživanja koje je nedavno sprovela Dr Suzan Babel, psiholog i specijalista za depresivne poremećaje ...

Napadi migrene mogu prouzrokovati snažne bolove, povraćanje i privremeni gubitak vida, a ono što je najgore je činjenica da još uvek ne postoji efikasan lek koji bi trajno pomogao obolelima u smanjenju ...

Crne krugove ispod očiju svi obično povezujemo sa umorom ili neispavanošću. Pojedine osobe imaju i genetsku sklonost za nastajanje podočnjaka, pa su od svojih roditelja ili deka i baka nasledili tu ne baš ...

U većini slučajeva odgađanje mokrenja neće biti po život opasno, međutim, lekari upozoravaju: ako to radite često i svakodnevno, zadržavanje mokraće će vremenom verovatno ostaviti posledice ...

Naučnici iz L'Oreal-a tvrde da bi se folikuli kose stvoreni novim biotehnološkim procesom veoma sličnom 3D štampanju, mogli uskoro koristiti kao zamena za implantate vlasišta. Čuvena kozmetička ...

Nemački naučnik i nobelovac Harald zur Hausen je nedavno objavio da je primećena veća učestalost oboljevanja od raka debelog creva u zemljama koje su počele masovno da uvoze i koriste goveđe ...

Kosu često ne cenimo dovoljno, sve do trenutka kada počnemo da ostajemo bez nje. Proverite da li su razlozi zbog kojih gubite kosu normalni ili vaše telo trenutno doživljava povećan stres.

Ne kaže se bez razloga da se majka priroda pobrinula za svaku našu aktivnost, posebno fiziološku. U želji da sebi olakša život i obavljanje nekih potreba učini socijalno prihvatljivim, čovek je promenio ...

U naučnim krugovima se već dugo špekuliše da soli aluminijuma koje se nalaze u dezodoransima, naročito antiperspirantima, direktno utiču na razvijanje raka dojke kod žena koje ove preparate ...

Osobe muškog pola koje pate od anksioznog poremećaja imaju dvostruko veći rizik da obole od nekog oblika karcinoma u poređenju sa onima koji nemaju takvih problema, pokazalo je nedavno ...

Zamrzavanje hrane u domaćinstvu je izuzetno star običaj i danas izuzetno raširen način čuvanja hrane, jer se namirnice jedino putem zamrzavanja mogu sačuvati u dužem vremenskom periodu, a da ...

Neposredno pre spavanja stavite malo ove smese pod jezik – spavaćete kao beba i nećete se buditi umorni. Smešu o kojoj govorimo je lako i jeftino napraviti, radi se zapravo o mešavini meda i ružičaste ...

Naučnici ipak navode da će biti potrebna dodatna istraživanja kako bi se do kraja razumela povezanost između vremena uzimanja obroka i rizika od nastanka gojaznosti. Međutim, za sada je jedino sigurno da ...

Gotovo petina žena starih između 35 i 44 godine ima problema sa začećem, a naročiti problem po pitanju fertiliteta češće imaju one žene koje kasnije zasnuju porodicu, pokazalo je ...

Oralna higijena je veoma važan deo naše svakodnevice, iako se mora reći da je često i zanemarivan. Zdravlje naših usta i zuba ima izuzetno značajno mesto u očuvanju zdravlja, bilo da je reč o načinu ...

Zahvaljujući flavonidima, antioksidantima koje u velikoj koncentarciji sadrže svi citrusi, a naročito limun, tretman poremećaja i ponovno normalizovanje organske funkcije kod oboljenja ...

Direktor Kancelarije za hematološke i onkološke proizvode iz FDA Centra za evaluaciju i istraživanje lekova, Dr Ričard Pazdur izjavio je nedavno da je novootkriveni lek za tretman malignih ...

Prema podacima Svetske zdravstvene organizacije (SZO), oko 30 odsto svetske populacije pati zbog različitih problema sa venama. Proširene (varikozne) vene sa udruženim simptomima i ...

Moderne tehnologije i dostupnost koja traje celih 24 sata dovele su nas do toga da neprestano proveravamo pristigle mejlove i sms poruke, ne praveći pauzu ni tokom vikenda i godišnjeg ...

Čitanje knjiga može produžiti životni vek za čak dve godine, navode naučnici sa Univerziteta Jejl, koji su rezultate svog nedavno sprovedenog istraživanja objavili u časopisu Social Science & Medicine. Koautorka ...

Australijski naučnici su jasni - veza između pola bebe i ishoda trudnoće sad je dokazana, pa su tako komplikacije i u trudnoći i nakon porođaja češće ako nosite dečaka. Nova velika studija ...

Ako ste redovno svaki dan odvajali pet minuta kako biste zube dodatno očistili zubnim koncem, možda ste gubili vreme, navodi se u rezultatima nedavno sprovedenog istraživanja. Naime, novo istraživanje ...

Evropska agencija za hemikalije otkrila je da u mastilima za tetovažu postoje opasne supstance koje mogu biti uzročnik raka, a rezultate će uskoro objaviti, najavivši moguće restrikcije za njihovu ...
Naučnici smatraju da će uskoro jedan jednostavan test ličnosti moći da pokaže rane znake Alchajmerove bolesti. Raspoloženje i ponašanje osobe može da se promeni mnogo pre nego ...

Možda još nije kasno da se dovedete u red pre nego što se skinete na nekoj plaži, pogotovo ako ste u generalno dobroj formi. Naime, ovih 9 namirnica ubrzaće Vaš metabolizam i pomoći Vam ...

Većina onih koji žele da smršaju i izgube suvišne kilograme, već odavno znaju pravilo da tokom dijete slatka i gazirana pića treba zameniti običnom vodom. Međutim, ono što svakako ...

Jedan sat fizičke aktivnosti srednjeg intenziteta tokom dana je više nego dovoljan da bi se poništio poguban učinak sedenja za stolom ili gledanjem televizije, rezultati su nedavno ...

Poznata je od davnina kao prirodni lek protiv bolova, a pomaže i kod raka jer zaustavlja njegovo širenje. Kurkuma sadrži polifenol - supstancu od koje telo ima više od 600 zdravstvenih koristi.

Uprkos ustaljenom mišljenju, smrznutu hranu možete konzumirati bez ikakvog straha. Istraživanje koje je na 1500 ispitanika sprovela britanska Agencija za kontrolu namirnica, pokazalo je da 43% ...

Sedeće godine revolucionarni uređaj, koji je veličine pećnice, ulazi u fazu završnih kliničkih ispitivanja, a u roku od tri godine planirali su izaći na tržište. “ARTIDIS” će se koristiti u klinikama na odeljenjima ...

Stručnjaci i lekari već godinama, ako ne i decenijama, ističu važnost povremenog dremanja i odmora usred dana. Dugo se smatralo da kratki predah u kojem se opustimo, zatvorimo oči i eventualno ...

Promena navika u vezi sa zdravljem i svakodnevno pridržavanje samo četiri jednostavna životna pravila moglo bi drastično smanjiti rizik oboljevanja od najčešćih vrsta karcinoma, zaključak je istraživanja ...

Ukoliko spadate među osobe koje se nakon svakog obroka osećaju loše, teško i kao da “nešto nije u redu”, i ako imate problema sa osećajem nadutosti, gorušicomi grčevima – nemojte biti previše zabrinuti, ...

Broj osoba obolelih od cijelakije je u stalnom porastu u celom svetu. Proizvodnja bezglutenske hrane je prema nedavno objavljenim podacima u SAD takođe u porastu – u periodu od 2013-2015. ...

Istraživači sa Državnog Univerziteta u Ohaju su dokazali da paracetamol ne samo što ublažava bol, već i umanjuje osećaj empatije za druge osobe koje trpe bol. Naime, prema rezultatima ...

Novo istraživanje iz oblasti genetike psihičkih poremećaja objavljeno u časopisu JAMA Psychiatry ukazuje na potencijalnu povezanost između nastanka bipolarnih poremećaja, šizofrenije i ...

“Jedi, pij i raduj se", kaže jedna stara poslovica. Ali, sudeći prema rezultatima nedavno objavljenog istraživanja, možda i nećete biti tako dugo srećni, bar kad je konzumiranje alkoholnih pića ...

Trudnice koje su se tokom trudnoće vakcinisale protiv gripa značajno smanjuju mogućnost da se njihovo novorođenče zarazi virusom gripa u toku prvih šest meseci života, zaključak je istraživanja ...

Nova klasa lekova koja napada kancerske ćelije na indirektan način putem destabilizacije proteina neophodnih malignim ćelijama za život i umnožavanje, obećava značajan uspeh u borbi protiv ...

Sudeći prema najnovijem naučnom izveštaju Američkog instituta za istraživanje raka (American Institute for Cancer Research - AICR) i Svetskog fonda za istraživanje malignih bolesti ...

Većina ljudi je iskusila tzv. “efekat prve noći” nekada u svom životu. Kada spavamo na nepoznatom krevetu po prvi put, verovatno će nam trebati više vremena da zadremamo, a i kada zaspimo, to ...

Nedavno sprovedeno istraživanje je pokazalo da mladi muškarci gejmeri koji se najviše poistovećuju sa glavnim likovima u seksističkim, nasilnim video igricama imaju manje empatije od drugih gejmera ...

Parkinsonova bolest je degenerativno oboljenje centralnog nervnog sistema, a simptomi uključuju intenzivan tremor, uglavnom šaka, ruku, donjih ekstremiteta, lica i vilica. Nastanak ovih poremećaja ...

Bolesti desni su glavni razlog gubitka zuba u odrasloj populaciji i veliki profesionalni izazov za zdravstvene stručnjake. Nedavno sprovedena studija o oboljenjima desni objašnjava razloge zbog kojih ...

Reiki je oblik alternativne terapije mnogo poznatije pod nazivom “isceljivanje energijom”. Ova terapijska tehnika je razvijena početkom 20-ih godina u Japanu i podrazumeva primenu transfera ...

Verovatno Vam i nije potrebno neko naročito opravdanje zbog čega imate običaj i volite da popijete šolju jake crne jutarnje kafe, ali nedavno sprovedeno istraživanje Vam nudi jedno dovoljno ...

Otkrivanjem genetskog koda virusa koji gotovo svi nosimo u našem telu možemo stvoriti ličnu mapu svih naših putovanja, tvrde istraživači koji su naškli genetski dokaz da i dva različita ...

Teški oblici srčanog udara sve češće pogađaju pripadnike mlađe populacije, a istovremeno se među mladim osobama sve češće registruje gojaznost, hipertenzija, dijabetes i hronična opstruktivna ...

Mamografija može da pomogne u proceni rizika za nastanak srčanih obollenja kod žena pomoću detektovanja naslaga kalcijuma u arterijama dojki i na taj način omogući ranu prevenciju potencijalnog ...

Istraživači veruju da su konačno nadomak stvaranja prve kontraceptivne pilule za muškarce na svetu. Put stvaranja “antibebi” pilula za jači pol nije bio nimalo lak, a rukovodilac studije Dr Gunda Georg ...

Svake godine širom Evrope i SAD se zabeleži desetine hiljada novih slučajeva karcinoma dojke povezanih sa povećanim konzumiranjem alkohola, a konzumiranje alkoholnih pića značajno povećava ...

Od trenutka kada se pojavio na tržištu sredinom 90-ih godina prošlog veka, Viagra (sildenafil) je preparat koji se često koristi u tretmanu erektilne disfunkcije kod muškaraca. Međutim, nedavno ...

Pitate se kako da svedete na najmanju moguću meru šanse da obolite od Alchajmerove bolesti? Zgrabite patike i idite u teretanu, prošetajte nekoliko krugova po parku ili otplešite nekoliko ...

Nedavno objavljena studija uliva nadu da se ipak može umanjiti stepen gubitka kognitivnih funkcija u starosti: naime, očuvanje saznajnih funkcija je, prema otkriću naučnika, u direktnoj vezi sa intelektualnom ...

Zika virus verovatno napada neuronski tip stem ćelija koje su zadužene za razvoj moždane kore, navodi se u istraživanju objavljenom u časopisu Cell Stem Cell. Svetska zdravstvena organizacija (WHO) je nedavno ...

Novo istraživanje otkriva na koji način tzv. “pametna” sočiva mogu pomoći u otkrivanju individualnih sklonosti za pogoršanje bolesti kod obolelih od glaukoma, vodećeg uzroka slepila u ...

Konzumiranje suvih šljiva može pružiti zaštitu od gubitka koštane mase koju prouzrokuje jonizujuće zračenje, tvrdi se u novoj studiji koja je objavljena u časopisu ...

Svakodnevno konzumiranje kafe smanjuje rizik od nastanka ciroze jetre, a ispijanje dve dodatne šoljice može gotovo prepoloviti incidence umiranja zbog ovog oboljenja, navode naučnici u istraživanju koje je nedavno ...

Naučnici su izrazili zabrinutost u vezi sa trenutnom modom pribegavanja slavnih ličnosti držanju raznih dijeta koje nemaju naučnu osnovu, i uticaja koji takvi njihovi postupci imaju na opštu populaciju, a na osnovu ...

Ispijanje boce soka od brusnice u slučaju dobijanja urinarne infekcije možda i nije baš toliko od pomoći, kako se do sada mislilo. Iako je ovaj recept popularan poslednjih destek godina, straživanje objavljeno u ...

Brz i precizan test koji može da detektuje prisustvo biomerkera raka pluća u pljuvački će uskoro biti primenjen i kod pacijenata posle opsežnih pretkliničkih istraživanja. Ovaj test koji će najverovatnije postati ...

Erektilna disfunkcija je verovatno jedno od najstresnijih iskustava koje muškarac može da doživi u svoim životu. Međutim, novo istraživanje ukazuje da konzumiranje svežeg voća bogatog flavonidima ...

Visok krvni pritisak je orgoman i nažalost, rastući zdravstveni problem širom sveta. Studija koja je nedavno objavljena prati odrastanje oko million i po tinejdžera u cilju otkrivanja uloge i značaja psiholoških ...

Zvaničnici iz četiri latinoameričke i karipske države su upozorili ženski deo populacije da ne planiraju trudnoću zbog zabrinutosti u vezi sa virusom koji izaziva nastanak anomalija u razvoju ploda ..

U istraživanju objavljenom u časopisu Cerebral Cortex, tvrdi se da konzumacija marihuane u adolescentnom periodu može dovesti do promena u mozgu, nalik onima koje postoje kod osoba obolelih ...

Rezistencija na antibiotike predstavlja sve veću javnozdravstvenu opasnost. Svetska zdravstvena organizacija (WHO) je 2014. godine upozorila da smo na putu ka „post-antibiotskom dobu“, u kome će infekcije ...

Ukoliko biste tragali za otkrićem novog efikasnog antibiotika, gde biste započeli istraživanje? Da li bi Vam ikada pala na pamet muška brada? Kao što ste primetili, brade su ponovo u modi. Tanke, “jareće”, pune ...

Vakcina koja se koristi za prevenciju karcinoma grlića materice može da ima mnogo širu primenu prema rečima stručnjaka. Ova vakcina će sada biti ponuđena i gay muškarcima mlađim od 45 godina ...

Česta upotreba čipsa i drugih proizvoda od krompira u ishrani može značajno povećati rizik od nastanka dijebetesa u trudnoći, saopštili su američki istraživači, a ova tvrdnja se zasniva na činjenici da je krompir ...

Provera moždane aktivnosti putem registracije EEG zapisa pre podvrgavanja pacijenata operativnom zahvatu može pomoći anesteziolozima u odabiru adekvatne vrste i doze anestetika, navode ...

U časopisu PLOS One istraživači su objavili otkriće da žene koje su više puta rađale imaju duže telomere od onih sa manje dece. I dok je majčinstvo veliko životno iskustvo i biološki smisao postojanja ...

Povećanje stope gojaznosti i nezdrave telesne težine može postati neposredan uzrok 670.000 slučajeva oboljevanja od malignih bolesti u narednih 20 godina, prema predviđanjima stručnjaka iz ...

Šta može prouzrokovati zavisnost od fejsbuka? U novoj studiji koja je sprovedena u cilju proučavanja mehanizama nastanka zavisnosti od društvenih mreža, istraživači su istakli da postoji jasna ...

Takozvana hirurgija gojaznosti može smanjiti rizik od nastanka šećerne bolesti i srčanog udara, podjednako uspešno kao i u suzbijanju same gojaznosti, navodi se u najvećoj uporednoj studiji o barijatrijskoj ...

Naučnici iz Istraživačkog centra za oralno zdravlje (CRC) Univerziteta u Melburnu, Australija, testirali su 23 različite vrsta napitaka bez šećera, uključujući bezalkoholna i sportska pića i došli do sledećeg ...

Lekari su saopštili ohrabrujuću vest: godišnja preventivna analiza krvi može da prepolovi broj umrlih osoba od carcinoma jajnika za polovinu. Karcinom jajnika je jedna od ...

Sudeći prema članku objavljenom u časopisu Cell Host and Microbe, naučnici su konačno otkrili mehanizam kojim se reaktivira virus herpesa i nastaju herpesne promene na koži u stresnim ...

Ibuprofen je jedan od najčešće korišćenih lekova u borbi protiv bolova različitog uzroka, otoka zglobova i povišene temperature. Iako stručnjaci stalno upozoravaju na mogućnost pojave neželjenih ...
dostupna-zastita-od-HIV-infekcije5786.jpg)
U ne tako davnoj prošlosti, naučnici koji su se bavili HIV problematikom su , za razliku od većine drugih koji su obično skloni tzv. "pronalazačkoj euforiji", spadali u grupu staloženijih i opreznijih ...

Mentalni poremećaji u detinjstvu i psihogena gojaznost su javnozdravstveni problemi u celom svetu. S obzirom na činjenicu da nastaju u detinjstvu, zdravstveni zvaničnici širom sveta upozoravaju ...

Osteoartritis je oboljenje od koje na globalnom nivou pati oko dve trećine osoba straijih od 65 godina. Prema poslednjim procenama, oko 52,5 miliona odraslih osoba u SAD boluje od nekog oblika artritisa, sa ...

Nova studija koja je sprovedena i objavljena na Univerzitetu Kardif obuhvatila je uzorak od pet hiljada dece uzrasta 9 do 11 godina, a dobijeni rezultati su pokazali očiglednu pozitivnu vezu između konzumiranja ...

Neuobičajen ili izvitoperen smisao za humor može biti rani znak razvoja demencije, saopštili su stručnjaci za ovo oboljenje iz Velike Britanije. Univerzitetski koledž iz Londona je sproveo istraživanje u kome ...

Prva osoba na svetu koja je primila novootkrivenu genetsku terapiju, pionirsku metodu u lečenju malignih bolesti, izborila se sa karcinomom i sada se oseća dobro. Jednogodišnja Lajla Ričards koja ...

U okviru akcije obeležavanja Meseca karcinoma dojke ovog oktobra širom sveta , brojne dobrotvorrne i druge organizacije koje se bave prevencijom karcinoma su “mislile ružičasto”. Ružičasta boja ...

Federalna agencija za lekove SAD (FDA) je dozvolila upotrebu novog singl preparata za kompletan tretman HIV – 1 infekcije kod obolele dece starije od 12 godina i odraslih HIV pozitivnih ...

Istraživači su razvili novu vrstu testa koji, kako navode, može uspešno predvideti seksualnu orijentaciju muškaraca, odnosno da li će biti homoseksualan i heteroseksualan. Otkriće je nedavno ...

Dobrobiti neposrednog kontakta novorođenčadi sa majkom neposredno posle rođenja su već dobro poznate i dokumentovane brojnim studijama. A šta se događa ...

Nova metoda za ponovno uspostavljanje rasta kose primenom lekova koji su već u kliničkoj primeni će uskoro verovatno biti primenjivana i u praksi, sudeći prema ...

Istraživači Odeljenja za ginekologiju i akušerstvo Univerzitetskog medicinskog centra u Frajburgu su razvili metodu detekcije carcinoma dojke iz uzorka mokraće. Metoda se ...

Studija koju je sprovela Vlada SAD je donela ohrabrujuće vesti za sve zabrinute roditelje – primena vakcina izuzetno retko može biti okidač za nastanak ozbiljnih i potencijalno ...

Polno prenosive bolesti danas predstavljaju nastaju prenošenjem bakterija, virusa ili parazita seksualnim putem. Zbog teških posledica koje mogu da ostave i činjenice ...

Ne pušite. Uopšte gledano, živite zdravim životom, tako da se i ne brinete u vezi sa nezdravim navikama jer smatrate da za to nemate razloga, zar ne?

Svakodnevna dešavanja i novi slučajevi nasilnog ponašanja u populaciji adolescenata svakako daju povoda za zabrinutost. Svedoci smo da nasilje među mladima neretko ...

Istraživanja pokazuju da se gotovo trećina slučajeva oboljevanja od karcinoma u Britaniji može sprečiti zdravijim stilom življenja, redovnim upražnjavanjem fizičkih aktivnosti ...

Da li je alkoholizam jedan od oblika depresivnog poremećaja ili samo izaziva pojavu depresije kod osoba koje za njen nastanak već imaju genetsku predispoziciju?

Kada se uzima oralno, lek se dobro toleriše sa ograničenom toksičnošću. Intravenska primena, ubrizgana unutar lipozoma, bila je podjednako efikasna sa manje sporednih efekata.

Dana 29. jula 2014. godine, američki Institut za medicinu ( IOM ) objavio je svoj izveštaj o upravljanju i finansiranju diplomiranih studenata medicine (GME).

Rezultate vakcine poznate kao VSV – EBOV objavljene u jednom uglednom časopisu zdravstveni zvaničnici nazvali su - uzbudljivim.

Antidepresivi , prema novoj studiji, mogu da utiču na mozak pacijenta u roku od samo tri sata. Naučnici su testirali lek koji se najčešće propisuje – escitalopram, reklamiran kao Cipralex u Velikoj Britaniji ...

Lek za tip 1 dijabetesa na dohvat ruke nakon otkrića koje bi moglo da znači kraj upotrebi insulina za milione ljudi.Ljudske matične ćelije su pretvorene u zrele Beta ćelije ...

Otkad je degenerativna bolest oka potpuno oštetila vid Larija Hestera, ranih 1980.-tih, on je živeo u tami. Ali pre par nedelja, gospodin Hester ...

NJUJORK (Reuters Health) - onlajn organizacija od više od 1.500 volontera koristi 3D štampače za proizvodnju protetičkih ruku ili prstiju za ljude širom sveta kojima su potrebni.

Pogledajte u ovom članku prikaze hrane koju unosimo i za koje je neizmerno zdrava i isto tako neobično podseća na njih. Tu je i pored raznog voća i povrća i vino...

Predstavljamo vam 10 najvažnijih otkrića u medicini u 2013. godini po izboru magazina TIME. Naime, Kako navodi magazin TIME slede top 10 medicinskih otkrića ...

Istraživači na Univerzitetu u Kaliforniji, u Los Anđelesu (UCLA ), su pronašli način da izazovu delovanje lekova protiv raka unutar tumora da bi se potencijalno ...
Pratite nas